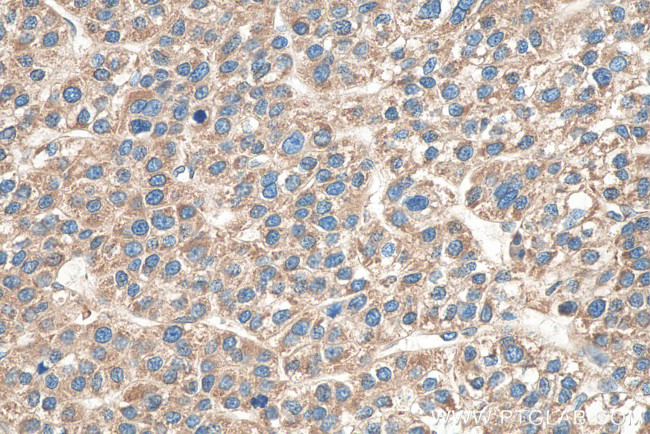
VAPA Antibody in Immunohistochemistry (Paraffin) (IHC (P))

Search
Proteintech
VAPA Monoclonal Antibody (1F10F9)
{{$productOrderCtrl.translations['antibody.pdp.commerceCard.promotion.promotions']}}
{{$productOrderCtrl.translations['antibody.pdp.commerceCard.promotion.viewpromo']}}
{{$productOrderCtrl.translations['antibody.pdp.commerceCard.promotion.promocode']}}: {{promo.promoCode}} {{promo.promoTitle}} {{promo.promoDescription}}. {{$productOrderCtrl.translations['antibody.pdp.commerceCard.promotion.learnmore']}}
产品信息
67845-1-IG
种属反应
宿主/亚型
分类
类型
克隆号
抗原
偶联物
形式
浓度
规格
纯化类型
保存液
内含物
保存条件
运输条件
产品详细信息
Aliquoting is unnecessary for -20°C storage.
靶标信息
The protein encoded by this gene is a type IV membrane protein. It is present in the plasma membrane and intracellular vesicles. It may also be associated with the cytoskeleton. This protein may function in vesicle trafficking, membrane fusion, protein complex assembly and cell motility. Alternative splicing occurs at this locus and two transcript variants encoding distinct isoforms have been identified.
仅用于科研。不用于诊断过程。未经明确授权不得转售。
篇参考文献 (0)
生物信息学
蛋白别名: 33 kDa VAMP-associated protein; 33kDa (Vesicle Associated Membrane Protein)-associated protein; epididymis secretory sperm binding protein; synaptobrevin-associated protein of 33kDa; unnamed protein product; vamp; VAMP (vesicle-associated membrane protein)-associated protein A, 33kDa; VAMP-A; VAMP-associated protein A; VAP-33; VAP-A; vesicle-associated membrane protein, associated protein a; Vesicle-associated membrane protein-associated protein A
基因别名: 33kDa; hVAP-33; VAMP-A; VAP-33; VAP-A; VAP33; VAPA
UniProt ID: (Human) Q9P0L0, (Rat) Q9Z270, (Mouse) Q9WV55
Entrez Gene ID: (Human) 9218, (Rat) 58857, (Mouse) 30960